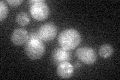
YDR424C
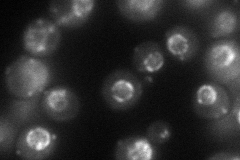
YDR424C
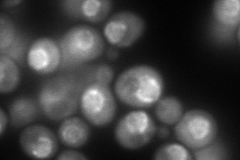
YDR424C
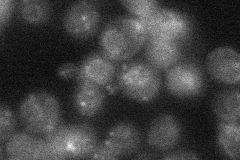
YDR424C
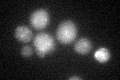
YDR424C
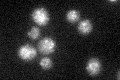
YDR424C

View description
Cytoplasmic light chain dynein, microtubule motor protein; proposed to be involved in the assembly of the nuclear pore complex
Localization:
Intensity:
Fold change:
Significance:
-
C’ GFP library in SD
ER27.32 -
N' NOP1pr-GFP in SD
punctate,nuclear periphery80.5427 -
N' TEF2pr-mCherry in SD
punctate,nuclear periphery222.607 -
N' NATIVEpr-GFP in SD
ER,punctate23.9928 -
N' TEF2pr-VC and Cyto-VN in SD

punctate,nuclear periphery76.4242 -
C’ GFP library in SD+DTT
ER25.890.94No -
C’ GFP library in SD+H2O2

ER21.720.79No -
C’ GFP library in Starvation Media
ER32.741.19No -
C’ GFP library on the background of Pup2-DaMP

ER -
C’ GFP library on the background of CCT mutant

ER23.18060.848232No
